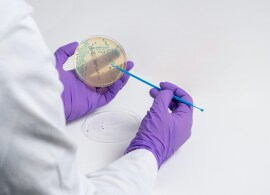
Next generation rapid culture media-based methods Next generation rapid culture media-based methods

Search
Search
During this year’s event we exhibited at Booth #337, showcasing our complete, validated workflow solutions that bring together the very best in food quality and safety testing. From market-leading molecular instrumentation, to streamlined culture media prep solutions and efficient chromogenic methods, we help food businesses to remain adaptive, responsive, and competitive. This year we focused on:
In your food safety testing workflow, time and resources matter. Thermo Scientific™ validated, alternative molecular methods combine streamlined efficiency with speed, value, and performance.
Keep Salmonella out of your facilities and products with our comprehensive range of validated solutions for detection, enumeration, identification, and serotyping.
Our unique microbiology heritage brings 100 years of expertise to our culture media portfolio. Discover why we are a preferred supplier to food labs globally.
Detection, Quantitation, and Serotyping of Salmonella from Poultry Samples with Harmonized Protocols | Poster number P1-273 |
Introduction: Salmonella contamination in poultry can pose significant health risks to consumers, therefore rigorous testing protocols are required to ensure safe consumption. Thermo Fisher Scientific offers a range of detection, quantitation, and serotyping PCR methods for fast and accurate detection and enumeration of Salmonella species and specific serotypes in poultry samples. Purpose: Harmonize test portion dilution and enrichment for raw poultry products and poultry rinses using the Thermo Scientific™ SureCount™ Salmonella species, Typhimurium and Enteritidis Multiplex PCR Kit (quantitation), Thermo Scientific™ SureTect™ Salmonella species PCR Assay (detection), Thermo Scientific™ RapidFinder™ Salmonella species, Typhimurium and Enteritidis Multiplex PCR Kit, and Thermo Scientific™ SureTect™ Salmonella Infantis PCR Assay (detection and serotyping) methods. |
Salmonella species Detection in Pet Food Using a Well-Established Real-Time PCR Method | Poster number P1-274 |
Introduction: Salmonella is a major global foodborne pathogen with a severe impact to public health. The Thermo Scientific™ SureTect™ Salmonella species PCR Assay provides an accurate and reliable method for the detection of Salmonella from a broad range of foods, environmental samples, primary production samples, pet foods and animal feeds. The SureTect Salmonella PCR method holds a number of certifications, including ISO 16140-2:2016 (AFNOR and MicroVal), and AOAC PTM and OMA. Purpose: Demonstrate the accuracy and reliability of the SureTect Salmonella PCR method for the detection of Salmonella in large sample sizes of pet food. |
Harmonized AOAC Ptm PCR Detection Workflows for Salmonella and STEC from 375 g Raw Beef and Leafy Produce Samples | Poster number P1-277 |
Introduction: Salmonella and Shiga-toxin producing Escherichia coli are important food pathogens in raw beef and leafy produce. A harmonized PCR workflow has been developed to enable detection of both pathogens from one short enrichment protocol using a large 375 g sample. Providing end users with a reliable, fast and streamlined method. Purpose: Develop and analyze a harmonized protocol for 375 g raw beef trim and leafy produce samples using the Thermo Scientific™ Salmonella species PCR Assay and the Thermo Scientific™ SureTect™ Escherichia coli O157:H7 and STEC Screening PCR Assay with the Thermo Scientific™ SureTect™ Escherichia coli STEC Identification PCR Assay. |
Harmonized large sample size (375 g) testing for detection of Salmonella and Cronobacter spp. in Powdered Infant Formula Using Thermo Scientific SureTect Salmonella PCR Assay and Thermo Scientific SureTect Cronobacter PCR Assay granted AOAC PTM | Poster number P1-275 |
Introduction: Annually, Salmonella and Cronobacter are responsible for over 200 million infections worldwide, with an outbreak of Cronobacter occurring in the US in 2022. One such source of infection is powdered infant formula (PIF), which is especially concerning for patients with suppressed immunity such as neonates, with case mortality reported to be 50-80%. Sensitive, easy, and reliable methods to detect Salmonella and Cronobacter spp. in PIF are of fundamental importance to reduce global disease burden. Purpose: To evaluate for AOAC PTM certification the Thermo Scientific™ SureTect™ Salmonella species PCR Assay and Thermo Scientific™ SureTect™ Cronobacter species Assay harmonized enrichment for large PIF sample sizes and environmental samples to detect Salmonella and Cronobacter spp. The harmonized enrichment involves a 1-in-6 dilution of sample of Buffered Peptone Water (with the addition of 6mg/L of Novobiocin for probiotic samples) with both assays run from the same lysate. |
A Study Design for Robust Comparison of 2 Workflow Options: Performance Equivalency for the Manual and Automated Workflows for Thermo Scientific™ SureTect™ PCR Assays | Poster number P1-272 |
Introduction: The Thermo Scientific™ SureTect™ Automation Platform offers a streamlined automated workflow for the Thermo Scientific™ SureTect™ assays to enable detection and differentiation of the most common food pathogens from various food and environmental samples. Purpose: A study design was developed to provide a robust comparison of the two workflows to validate the performance equivalency of the automated and manual methods. |
Detection of Campylobacter from Raw Milk and Raw Pork Using a Multiplex PCR Workflow | Poster number P1-276 |
Introduction: Campylobacter is the leading cause of gastroenteritis disease worldwide, is commonly associated with poultry products, and has been associated with outbreaks from raw milk and raw pork. The Thermo Scientific™ SureTect™ Campylobacter jejuni, C. coli and C. lari PCR Kit is used for the detection of three species from poultry matrices. It is proposed to verify the performance of the PCR workflow for the detection of Campylobacter from raw milk and raw pork. Purpose: The purpose of the study was to verify the performance of the SureTect molecular workflow for the detection of Campylobacter from raw milk and raw pork matrices. |
Detection of Shiga Toxin-Producing Escherichia coli in Raw Flour-Based Foods | Poster number P1-278 |
Introduction: Shiga toxin-producing Escherichia coli (STEC) outbreaks are typically associated with raw meat products and fresh produce. Flour has recently been a source of human illness caused by STEC. In 2018, a multi-state outbreak caused by contaminated flour resulted in three hospitalizations out of 21 reported cases. A survivability study assessing STEC contamination of flour found that 20% samples tested positive for the stx gene after two years’ storage. Screening of flour products for STEC may be used in effective risk mitigation strategies. Purpose: To verify performance of the Thermo Scientific™ SureTect™ molecular workflow versus a culture media method for detection of STEC in flour-based foods. |
Evaluation of Multiple Harmonized PCR Workflows for Detection of Bacteria from Infant Formula | Poster number P1-279 |
Introduction: The rapid and reliable detection of bacteria from liquid infant formula is vital to ensure these products are safe to consume, and product can be released to the market rapidly. Thermo Scientific™ SureTect™ rapid PCR workflows for a range of pathogens can be used to test these products including Salmonella, Cronobacter, and S. aureus. Purpose: This study evaluated the performance of five different PCR Assays for the detection of bacteria from liquid infant formula and demonstrates that a harmonized enrichment and lysis protocol can be used for those workflows, saving cost and time to the end user. |
Rapidly and accurately detect foodborne pathogens, and other important food safety and quality targets with the SureTect Food Safety PCR System. Empower your operations with a single enrichment step, simple workflows and rapid reporting.
Take your food safety testing to the next level with automated lysis and PCR setup using the SureTect Automation Workflow. Reduce hands-on time whilst increasing the accuracy and reproducibility of your results - whatever your lab’s throughput requirements.
Looking for a streamlined, validated alternative to resource-intensive, traditional culture media-based workflows? Thermo Scientific™ Precis™ and Brilliance™ Methods offer dramatically simplified, harmonized workflows with a sample-to-result time from just two days.
Choose easier, safer and more streamlined culture media preparation when preparing dilutions for direct testing or enrichment of food samples, with space-saving, easy-to-use irradiated media bags, pre-weighed culture media sachets and QC organisms you can trust.
In the fast-moving, high-volume, low margin business of poultry production, microbiological testing can eat into productivity and profitability.
Thankfully, Thermo Scientific solutions for the microbiological testing of poultry, provide everything laboratories need with products that meet the formulations stated in the relevant ISO, FDA-BAM and UDSA-FSIS reference methods.
From updates about our products and services to the latest breakthroughs in technology, expert opinion, consumer concerns and more. Visit our Food Safety and Authenticity Bulletin page, or sign up to be informed by email.